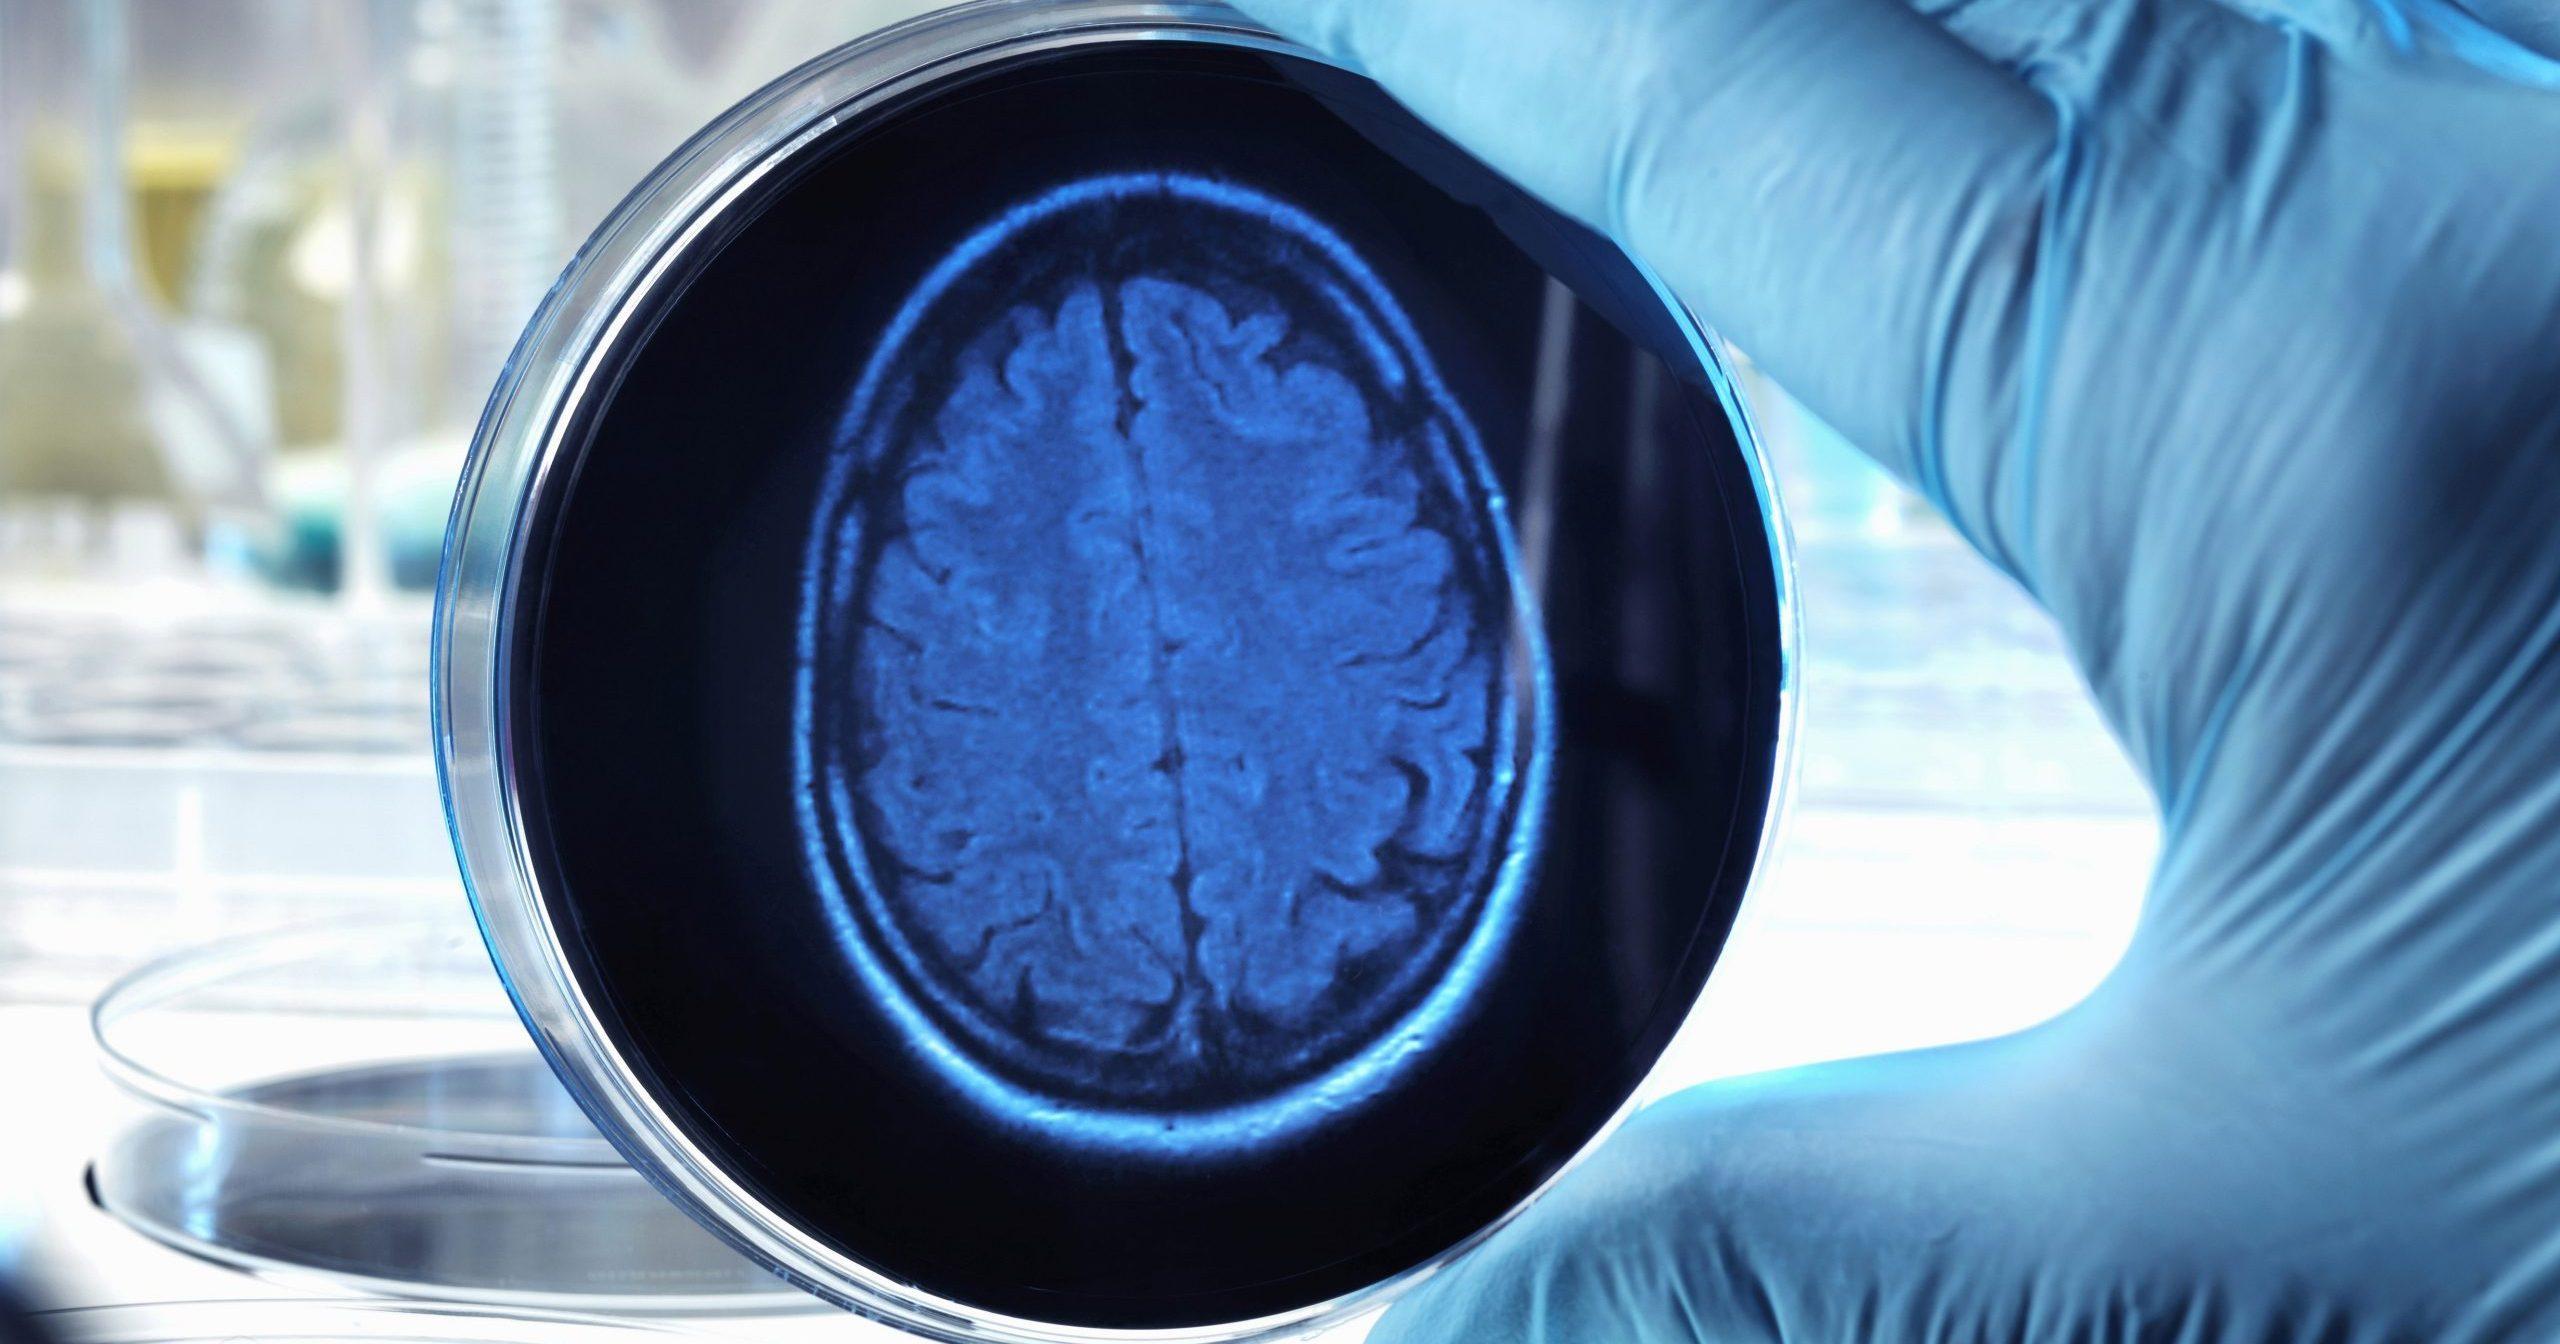

News
July 9, 2021
Muna Therapeutics Launches with US$ 73M Series A to Advance Novel Small Molecule Therapeutics for Neurodegenerative Diseases
Financing co-led by Novo Holdings, Sofinnova Partners, Droia Ventures and LSP Dementia Fund, with participation from Polaris Partners, Polaris Innovation Fund, Sanofi Ventures, V-Bio Ventures and VIB
Developing small molecules to repair neuronal dysfunction and resolve neuroinflammation
Innovative drug discovery platform leveraging insights from novel targets and pathways, resilience to neurodegeneration and all-in-human validation
Copenhagen, Denmark, 9th July 2021 – Muna Therapeutics (“Muna”), pioneering the development of first-in-class small molecule therapeutics for neurodegenerative diseases, today announced the successful closing of a US$ 73 million (EUR 60 million) Series A financing round. The investor syndicate was co-led by Novo Holdings, Sofinnova Partners, Droia Ventures and LSP Dementia Fund, with Polaris Partners, Polaris Innovation Fund, Sanofi Ventures, V-Bio Ventures and VIB joining the round.
Muna is the combination of two innovative European start-up companies. Muna was founded in 2020 by progranulin pathway thought leaders Professor Simon Glerup and his team from Aarhus University, Denmark, with investor Novo Holdings. Muna developed a strategic partnership on additional targets with Axxam SpA, based in Milan, Italy, which became a minority shareholder. Muna is part of Novo Seeds’ company creation efforts, where the Novo team and its entrepreneurs-in-residence help build new biotech companies based on groundbreaking new science.
Muna joined forces with K5 Therapeutics, co-founded in 2020 by Professor Bart De Strooper from VIB-KU Leuven, Belgium, a pioneer in neurodegenerative diseases research, with investors Droia Ventures and VIB. The combined company – Muna Therapeutics – will be based in Copenhagen and Leuven and is led by seasoned pharma executives CEO Rita Balice-Gordon and COO Anders Hinsby_,_ both entrepreneurs-in-residence of Novo Seeds.
Neurodegenerative diseases affect millions of individuals, with increasing global impact as the population ages. Palliative treatments are scarce, and no curative therapies are currently available. Muna is focused on addressing the staggering unmet need experienced by patients around the world with neurodegenerative disorders.
Muna’s innovative all-in-human target discovery and validation platform is based on proprietary insights into molecular pathways in different human brain cell types that underlie disease pathology and resilience to neurodegeneration, based on work from the De Strooper and Glerup laboratories. Muna has built a cutting-edge small molecule drug discovery engine that leverages high-resolution target structural approaches, AI-driven computational chemistry and cell-based screening. The financing will be used to advance Muna’s small molecule programs focused on repairing neuronal dysfunction, resolving neuroinflammation and restoring neuroprotection and resilience to disease to Investigational New Drug (IND) applications.
“We are in an era of rapid advancement in understanding how to slow or stop the relentless progression of neurodegenerative diseases like Alzheimer’s and Frontotemporal Dementia that devastate cognition and quality of life of patients as well as caregivers.” said Rita Balice-Gordon, Chief Executive Officer of Muna Therapeutics. “Our team is committed to leveraging our collective expertise to deliver impactful disease modifying small molecule therapeutics to patients as rapidly as possible.”
The Board of Directors includes: Morten Graugaard Døssing, Partner at Novo Holdings, current Chairman; Henrijette Richter, Managing Partner at Sofinnova Partners; Cillian King, Investment Manager at LSP; Luc Dochez, Partner at Droia Ventures; Isaac Ciechanover, Partner at Polaris Partners; Laia Crespo, Head of Investments at Sanofi Ventures; and Rita Balice-Gordon, CEO of Muna.
Morten Graugaard Døssing, Chairman of the Board and Partner at Novo Holdings, said: “Novo Seeds is delighted to welcome a global syndicate of first-class investors who strongly believe in Muna’s world-leading science, experienced leadership team, and its potential to develop innovative treatments for neurodegenerative diseases. We are honored to co-lead this round with Sofinnova Partners, Droia Ventures and LSP Dementia Fund – a tremendous joint effort to bring Muna to the next level.”
About Muna Therapeutics
Muna Therapeutics is a private biopharmaceutical company founded in 2020 and based in Copenhagen, Denmark and Leuven, Belgium. Muna discovers and develops therapies that slow or stop devastating neurodegenerative diseases including Alzheimer’s, Frontotemporal Dementia and Parkinson’s. These disorders impact memory, movement, language, behavior and personality resulting in disability and death of millions of patients around the globe. We focus our groundbreaking science on identifying new medicines to preserve cognition and other brain functions and enhance resilience to neurodegenerative diseases. Our name reflects this focus: Muna means ‘to remember’ in Old Norse. www.munatherapeutics.com
Investor Syndicate
About Novo Holdings
Novo Holdings A/S is a private limited liability company wholly owned by the Novo Nordisk Foundation. It is the holding company of the Novo Group, comprising Novo Nordisk A/S and Novozymes A/S, and is responsible for managing the Novo Nordisk Foundation’s assets.
Novo Holdings is recognized as a world-leading life science investor with a focus on creating long-term value. As a life sciences investor, Novo Holdings provides seed and venture capital to development-stage companies and takes significant ownership positions in growth and well-established companies. Novo Holdings also manages a broad portfolio of diversified financial assets. http://novoholdings.dk/.
About Sofinnova Partners
Sofinnova Partners is a leading European venture capital firm in life sciences, specializing in healthcare and sustainability. Based in Paris, London and Milan, the firm brings together a team of professionals from all over the world with strong scientific, medical and business expertise. Sofinnova Partners is a hands-on company builder across the entire value chain of life sciences investments, from seed to later-stage. The firm actively partners with ambitious entrepreneurs as a lead or cornerstone investor to develop transformative innovations that have the potential to positively impact our collective future. Founded in 1972, Sofinnova Partners is a deeply-established venture capital firm in Europe, with 50 years of experience backing over 500 companies and creating market leaders around the globe. Today, Sofinnova Partners has over €2 billion under management. www.sofinnovapartners.com.
About Droia Ventures
Droia is a specialist biotech investor with an exclusive focus on therapeutics for oncology and genetic disease. Droia invests globally in newly founded or early-stage platform companies that apply novel science and innovative technologies to bring first-in-class drug candidates to patients. With our team of seasoned scientists, entrepreneurs and investment professionals we build great companies to save patient lives. www.droiaventures.com.
About LSP
LSP is one of the largest European investment firms providing financing for life sciences and health care companies. LSP’s management has raised over €2 billion ($2.5 billion) and supported the growth of 300 companies since it started to invest in 1988, including signature deals such as argenx, Crucell and Neuravi. With offices in Amsterdam, Munich and Boston, LSP currently has the possibility to invest through five strategies, each having a distinctive investment scope and a dedicated team: LSP 6 invests in private early- to late-stage drug development and medical technology companies; LSP HEF 2 focuses on private late-stage medical technology companies; the LSP Dementia Fund invests in companies targeting neurodegenerative diseases; LSP Public targets public healthcare companies; and EBAC is the first healthcare SPAC to exclusively focus on European biotech. LSP is an active contributor to the global life sciences industry and the European life science eco-system by assuming for-profit and not-for-profit roles as initiators, founders and board members in various private and public bodies and organizations, for example being founder and board member of the Oncode Institute. www.lspvc.com.
About Polaris Partners and Polaris Innovation Fund
Polaris Partners has a 20-plus-year history of partnering with repeat entrepreneurs and world-class innovators who are improving the way we live and work. The multibillion-dollar firm manages specialty and diversified funds in healthcare and technology with investments across all stages. The Polaris Innovation Fund aims to accelerate the commercial and therapeutic potential of early-stage academic research. By partnering with passionate entrepreneurs with transformational science, the Polaris Innovation Fund fosters company creation and growth through an active investment model. Polaris has offices in Boston, San Francisco, and New York. www.polarispartners.com.
About Sanofi Ventures
Sanofi Ventures is the corporate venture capital arm of Sanofi. Sanofi Ventures invests in early-stage biotech and digital health companies with innovative ideas and transformative new products and technologies of strategic interest to Sanofi. Among these areas are oncology, immunology, rare diseases, vaccines, potential cures in other core areas of Sanofi’s business footprint, and digital health solutions. www.sanofiventures.com
About V-Bio Ventures
V-Bio Ventures is an independent venture capital firm specialized in building and financing young, innovative life science companies. V-Bio Ventures was established in 2015 and works closely with Belgium-based VIB, one of the world’s premier life science institutes. The fund invests throughout Europe in start-up and early-stage companies with high growth potential focusing on technologies that provide transformational improvements in the biopharmaceutical, pharmaceutical, diagnostics and agricultural sectors. www.v-bio.ventures.
About VIB
VIB is an entrepreneurial research institute in life sciences located in Flanders, Belgium. VIB’s basic research leads to new and innovative insights into normal and pathological life processes. It unites the expertise of all its collaborators and research groups in a single institute, firmly based on its close partnership with 5 Flemish universities (Ghent University, KU Leuven, University of Antwerp, Vrije Universiteit Brussel and Hasselt University). We are supported by a solid funding program from the Flemish government. VIB has an excellent track record on translating basic scientific results into pharmaceutical, agricultural and industrial applications. Since its foundation in 1996, VIB has created 29 start-up companies, now employing over 900 people. www.vib.be.
Further information
Muna Therapeutics
Rita Balice-Gordon, CEO
Email: balicegordon@munatherapeutics.com
Optimum Strategic Communications
Mary Clark, Manel Mateus, Stella Lempidaki
Tel: +44 (0) 20 3922 1906
Email: muna@optimumcomms.com